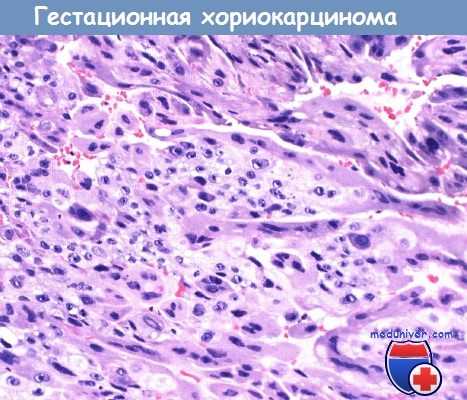
Гестационная хориокарцинома

Гестационная трофобластическая неоплазия (ГТН) - критерии диагностики, обследование
Добавил пользователь Валентин П. Обновлено: 08.11.2025
Гестационная трофобластическая неоплазия (ГТН) - критерии диагностики, обследование
Отсроченная диагностика злокачественной гестационной трофобластической неоплазии (ГТН) ухудшает исход заболевания и плохо влияет на эффективность лечения. Во всех случаях развития злокачественной гестационной трофобластической неоплазии (ГТН) необходимо полное обследование для выявления метастазов и других клинически важных прогностических факторов.
Для определения прогностических групп и индивидуального подбора лечения существует несколько классификаций. В 2000 г. эксперты FIGO пересмотрели систему стадирования злокачественных гестационных трофобластических неоплазий (ГТН) с учетом прогностических факторов, не связанных с анатомическими особенностями распространения опухолевого процесса. Внесенные изменения облегчают классификацию для отдельных пациенток.
От 1/2 до 2/5 случаев ГТН, требующих лечения, возникают после эвакуации ППЗ или ЧПЗ. Поскольку лечение пациенток проводят, ориентируясь на уровень ХГ, а не гистологическое исследование материала после гистерэктомии, точное распространение морфологических поражений неизвестно. Приблизительно у 50—70 % больных ГТН после эвакуации ПЗ развивается персистирующий или инвазивный ПЗ, у 30—50 % — гестационная хориокарцинома.
Абсолютное большинство других случаев злокачественной гестационной трофобластической неоплазии (ГТН) приходится на гестационную хориокарциному после доношенной беременности, самопроизвольного аборта и эктопической беременности.

a Сочетаются с метастазами в легких - локализацией самого большого риска.
b Повышение содержания ХГ после гистерэктомии по поводу ПЗ без выявленных метастазов.
Трофобластическая опухоль плацентарной площадки (ТОПП) — редкая форма ГТН, возникающая после беременности, закончившейся любым исходом.
Инвазивный пузырный занос (ПЗ) характеризуется отеком ворсин хориона с пролиферацией трофобласта, вторгающегося непосредственно в миомстрий. Возможны метастазы пузырьков заноса, но, как правило, инвазивный ПЗ самостоятельно рассасывается через много месяцев; для профилактики заболеваемости и смертности, связанной с перфорацией матки, кровотечением и инфекционными осложнениями, назначают XT. Гестационная хориокарцинома — исключительно эпителиальная злокачественная опухоль, состоящая из опухолевых элементов синцитио- и цитотрофобласта без ворсин хориона.
Для нее характерно раннее системное метастазирование, поэтому при установлении гистологического диагноза абсолютно показана XT.
Трофобластическая опухоль плацентарной площадки (ТОПП) встречаются относительно редко. Они характеризуются отсутствием ворсин с пролиферацией клеток промежуточного трофобласта. Клеток синцитиотрофобласта, как и при хориокарциноме, нет, и секреция ХГ относительно низкая. Большинство ТОПП в отличие от других форм злокачественной ГТН обладает низкой чувствительностью к простой XT, поэтому необходим точный гистологический диагноз. Хирургическому лечению ТОПП отводится ведущая роль. К счастью, у многих пациенток процесс ограничен маткой и операция в объеме гистерэктомии вполне достаточна для лечения.
После эвакуации пузырный занос (ПЗ) периодически определяют уровень ХГ, что дает возможность ранней диагностики ГТН. Напротив, пациентки со злокачественной ГТН после нормальной беременности часто поступают с симптомами, нехарактерными для заболеваний женских половых органов, например кровохарканьем, эмболией легочной артерии, геморрагическим инсультом, кровотечением из ЖКТ или мочевых путей либо массивной метастатической опухолью из неизвестного первичного очага.
В большинстве случаев в анамнезе имеются указания на нерегулярные маточные кровотечения, аменорею или недавнюю беременность. Однако эта опухоль может возникать через несколько лет после беременности или после самопроизвольного аборта, оставшегося нераспознанным. У любой женщины репродуктивного возраста, поступившей с метастазами из неизвестного первичного очага или недиагностироваппым кровоизлиянием в головной мозг, следует подозревать злокачественную ГТН.
Микропрепарат гестационной xoриокарциномы при большом увеличении.
Видны два типа клеток: полигональные клетки цитотрофобласта и многоядерные синцитиотрофобласта.
Постановка диагноза основана на принципе высокой онкологической настороженности, определении уровня ХГ в сыворотке и исключении беременности, при этом обычно биопсия тканей не требуется.
По данным Delfs, до появления эффективной XT после эвакуации ПЗ уровень ХГ оставался повышенным в течение 2 мес. примерно у 25 % женщин. После выскабливания матки наблюдали 119 пациенток, из них 5 (4 %) и 6 (5 %) выполнили гистерэктомию по поводу инвазивного ПЗ и хориокарциномы соответственно. По другим данным, смертность пациенток с инвазивным ПЗ до наступления эры XT составляла более 20 %. После появления эффективных цитостатических режимов XT 15—36 % женщин получают лечение после эвакуации ПЗ (основанием для назначения служит уровень ХГ) с целью снизить заболеваемость и смертность от ГТН.
Bagshawe и соавт. использовали строгие критерии для проведения XT; по их данным, после эвакуации ПЗ в лечении нуждалось всего 8 % женщин. Для установления диагноза ГТН после удаления ПЗ чаще всего используют характер снижения уровня ХГ в сыворотке. В большинстве случаев имеется первоначальное падение его концентрации; затем содержание ХГ определяют каждые 2 нед. Практически в каждом исследовании лечение пациенток начинали на основании документированного повышения уровня ХГ. Но во многих случаях к XT приступали при относительно короткой продолжительности плато содержания ХГ(< 3 нед.).

Микропрепарат трофобластической опухоли плацентарной площадки после гистерэктомии:
гладкие мышцы стенки матки инфильтрированы пластами анапластических полигональных клеток с частыми митозами.
Kohorn заметил, что у 15 % пациенток с наличием плато уровня ХГ после эвакуации ПЗ, длящимся не менее 2 нед., происходит спонтанное уменьшение его концентрации без какого-либо вмешательства.
Кроме того, при проведении клинического исследования XT гестационной трофобластической неоплазии (ГТН) дактиномицином Schlaerth и соавт. выявили значительное падение уровня ХГ у 25 % пациенток в день начала лечения, что указывает на отсутствие истинной ГТН после эвакуации ПЗ в некоторых случаях. На основе корреляции между уровнем ХГ и опухолевой массой Kphorn предложил подход, при котором при высоком уровне плато ХГ период наблюдения до начала XT должен быть коротким, а в случае плато ХГ < 1000 мМЕ/мл — длинным.
Lurain и соавт. из John I Brewer Trophoblastic Disease Center сообщили о собственном опыте лечения 738 пациенток с полным пузырным заносом (ППЗ). У 596 женщин наступило спонтанное снижение содержания ХГ до нормы, хотя у 390 (65 %) это происходило на протяжении 60 дней, а у других 206 пациенток — в течение последующих 110 дней. Среди всех женщин, участвовавших в исследовании, 142 (19 %) получили XT из-за повышения содержания ХГ или стабилизации его значений на уровне плато. При этом у 125 больных был инвазивный ПЗ, а у 17 — хориокарцинома.
Только у 15 % из 142 больных, получивших лечение, что составляет 3 % от общего числа пациенток, развились метастазы за пределами матки. Morrow и Kohorn при лечении большей части своих больных использовали критерии снижения ХГ, полученные из кривых регрессии, и сравнивали их с данными литературы об индивидуальном характере снижения этого гормона. Оказалось, что использование кривой регрессии ХГ приводит к лечению большего количества пациентов, чем необходимо, и не предотвращает развития метастатической болезни. У всех женщин в исследовании Lurain и соавт. сохранялась ремиссия независимо от способа ее наступления (спонтанная или терапевтическая).

Для создания универсальных рекомендаций по диагностике, обследованию и стадированию гестационной трофобластической неоплазии (ГТН) после эвакуации пузырного заноса (ПЗ) FIGO провела симпозиумы членов Society of Gynecologic Oncologists, International Society for the Study of Trophoblastic Disease и International Gynecologic Cancer Society. Современные критерии FIGO по диагностике ГТН после удаления ПЗ следующие:
1) четыре или более значений ХГ на уровне плато (± 10 %) в течение не менее 3 нед.: 1,7, 14 и 21-й дни;
2) повышение уровня ХГ > 10 % либо в 3 определениях или более в течение по крайней мере 2 нед.: 1, 7 и 14-й дни;
3) гистологический диагноз — хориокарцинома;
4) персистенция повышенного уровня ХГ более 6 мес. после эвакуации ПЗ.
Интенсивность и длительность наблюдения при наличии плато ХГ более 3 нед. определяет лечащий врач. Такая тактика разрешена, т. к. она не влияет на выживаемость.
Диагностика гестационной трофобластической неоплазии:
- После эвакуации ПЗ: 4-кратное или большее число определений ХГ в течение не менее 3 нед.показывает стабилизацию показателей на уровне плато (± 10%): 1, 7, 14и 21-йдни
- После эвакуации ПЗ повышение уровня ХГ > 10 % либо в 3 определениях или более в течение 2 нед.: 1, 7 и 14-й дни
- После эвакуации ПЗ стойкое повышение содержания ХГ на протяжении более б мес.
- Гистологический диагноз хориокарциномы, инвазивного ПЗ или ТОПП
- Метастатическая болезнь при неустановленном первичном очаге с повышением ХГ при исключении беременности
Обследование при гестационной трофобластической неоплазии (ГТН):
- Полное физикальное исследование, включая гинекологический осмотр; анализы крови, биохимические показатели функции печени и почек
- Исходное количественное определение ХГ
- Рентгенография или КТ грудной клетки
- МРТ или КТ головного мозга
- КТ брюшной полости и таза
В большинстве центров в США также проводят лечение пациенток при выявлении метастазов во время обследования или рентгенологических исследований. Некоторые легочные метастазы возникают в результате циркуляции трофобласта во время эвакуации ПЗ. Поэтому наличие на рентгенограмме очаговых теней в легких не всегда отражает злокачественное поведение опухоли.
Bagshawe и соавт. представили результаты централизованной системы наблюдения за больными после эвакуации пузырного заноса (ПЗ) (Великобритания) и сообщили о консервативном ведении больных с очаговыми тенями в легких с принятием решения о лечении на основании характера снижения уровня ХГ. Несмотря на отличные результаты такого подхода, точных данных о пациентках с метастазами в легких нет. В США, где лечение проводят децентрализованно и большинство пациенток после эвакуации ПЗ наблюдаются акушерами-гинекологами, показанием для начала лечения служит наличие метастазов.

Редактор: Искандер Милевски. Дата обновления публикации: 18.3.2021
Трофобластическая болезнь
Трофобластическая болезнь – общее понятие, объединяющее различные формы ассоциированной с беременностью пролиферативной неоплазии трофобласта. Термин «трофобластическая болезнь» включает в себя пузырный занос (частичный и полный), инвазивный пузырный занос, хорионкарциному, эпителиоидную трофобластическую опухоль, трофобластическую опухоль плацентарной площадки. Диагностика трофобластической болезни основывается на данных УЗИ и КТ, исследования концентрации ХГЧ в крови. Лечение может включать эвакуацию пузырного заноса, химиотерапию, гистеротомию.

Общие сведения
В гинекологии трофобластическая болезнь является довольно редкой патологией и встречается в 1—2,5% случаев; ее развитие ассоциировано с беременностью; первичной локализацией практически всегда служит матка. Среди различных форм трофобластической болезни на полный пузырный занос приходится 72,2% случаев; на частичный – 5%; на хорионкарциному - 17,5%, другие виды - 5,3%. При трофобластической болезни возникают пролиферативные аномалии наружного слоя клеток зародыша, участвующих в формировании эпителиального покрова ворсин хориона. Возникновение трофобластической болезни возможно как во время гестации, так и после завершения беременности. Трофобластическая болезнь может иметь доброкачественное или злокачественное течение.
Классификация трофобластической болезни
Международная классификация различает доброкачественные формы трофобластической болезни (частичный и полный пузырный занос) и злокачественные неоплазии (инвазивный пузырный занос, хорионкарциному, трофобластическую опухоль плацентарного ложа, эпителиоидноклеточную трофобластическую опухоль). Злокачественные неоплазии могут иметь неметастазирующее и метастазирующее клиническое течение низкой либо высокой степени риска.
Согласно клинической классификации FIGO, выделяют следующие стадии трофобластической болезни:
- I – локализация трофобластического новообразования ограничена маткой
- II – трофобластическая неоплазия распространяется на широкую связку матки, придатки, влагалище, но ограничивается гениталиями.
- III – кроме поражения половых органов, определяются метастазы в легкие
- IV – кроме легочных метастазов, определяются поражения селезенки, почек, ЖКТ, печени, головного мозга.
Причины развития трофобластической болезни
Различные формы трофобластической болезни рассматриваются онкогинекологией как единый этиопатогенетический процесс. Среди этиологических предпосылок трофобластической болезни не исключаются особые свойства яйцеклетки, влияние вирусов (в частности, вируса гриппа) на трофобласт, иммунологические факторы, повышение активности гиалуронидазы, хромосомные аберрации, дефицит белка.
Замечено, что вероятность развития трофобластической болезни в 5 раз выше у женщин старше 40 лет, чем у женщин до 35 лет. Среди других факторов риска выделяют наличие в анамнезе эпизодов самопроизвольного прерывания беременности, абортов, внематочной беременности, родов. В географическом плане трофобластическая болезнь чаще развивается у жительниц Востока, чем у представительниц западных стран.
Шансы на развитие хорионкарциномы значительно возрастают после перенесенного пузырного заноса по сравнению с нормально протекающей беременностью. В свою очередь, вероятность развития инвазивного пузырного заноса выше после полной формы пузырного заноса, чем после частичной. Трансформация структур трофобласта может развиваться в процессе беременности (нормальной или эктопированной) либо после завершения гестации (родов, выкидыша, аборта).
Симптомы трофобластической болезни
Клиника пузырного заноса характеризуется влагалищными кровотечениями (90%); превышением размеров матки должной величины, соответствующей сроку гестации (50%); двусторонними текалютеиновыми кистами более 8 см в диаметре (до 40% случаев). Течение пузырного заноса может осложняться токсикозом беременных (неукротимой рвотой), артериальной гипертензией, преэклампсией, признаками гипертиреоза (гипертермией, тахикардией и др.), разрывом овариальных кист, профузным кровотечением. В редких случаях при данной форме трофобластической болезни развивается ТЭЛА, ДВС-синдром.
Клиническими особенностями инвазивного пузырного заноса служит инфильтративный рост, высокая вероятность трансформации в хорионкарциному, в трети случаев - метастазирование в вульву, влагалище, легкие. Трофобластическая хорионкарцинома способна глубоко инфильтрировать и разрушать стенку матки, поэтому обычно первым проявлением данной формы трофобластической болезни служит массивное кровотечение. Хорионкарцинома обладает высокой частотой метастазирования в легкие, органы малого таза, печень, селезенку, головной мозг, почки, желудок, обуславливая соответствующую клиническую симптоматику.
Трофобластическая опухоль плацентарного ложа обладает инфильтрирующим ростом, что сопровождается разрушением серозного покрова матки, кровотечениями; может метастазировать во влагалище, брюшную полость, головной мозг. Эпителиоидноклеточная трофобластическая опухоль чаще имеет локализацию в области дна матки и в цервикальном канале, что может проявляться признаками, типичными для рака тела или шейки матки. Данная форма трофобластической болезни нередко манифестирует спустя несколько лет после беременности, заявляя о себе наличием отдаленных метастазов.
В связи с наличием метастазов могут отмечаться головные боли, боли в грудной клетке, кашель с выделением кровянистой мокроты, желудочные кровотечения, кишечная непроходимость, парезы, интоксикация, анемия, кахексия и т. д. При различных формах трофобластической болезни могут возникать боли в животе, связанные с прорастанием опухолью параметрия, сдавлением нервных стволов, перфорацией матки, разрывом или перекрутом ножки кисты.
Диагностика
В анамнезе у всех пациенток с трофобластической болезнью отмечается беременность, завершившаяся абортами (искусственными или самопроизвольными), родами, тубэктомией по поводу внематочной беременности. Большинство пациенток жалуется на аменорею, ациклические маточные кровотечения, олигоменорею, меноррагии, боли в животе или груди, головную боль, кровохарканье, кашель. Во время гинекологического исследования обнаруживаются увеличенные размеры матки, не соответствующие должному сроку беременности или послеродового периода. Нередко гинекологу удается пропальпировать опухолевые узлы в матке, малом тазу, влагалище.
Использование трансвагинального УЗИ позволяет обнаружить опухоли трофобласта с минимальным размером 4 мм. Патогномоничным признаком трофобластической болезни является обнаружение текалютеиновых кист яичников, часто больших размеров. Концентрация ХГЧ в плазме крови при трофобластической болезни всегда повышена. Важнейшим критерием диагностики трофобластической болезни служит морфологическое исследование тканей, полученных в ходе диагностического выскабливания матки, лапароскопии, иссечения опухолей стенки влагалища, пункции метастазов.
С помощью вспомогательных методов (УЗИ брюшной полости, печени, почек; КТ, ПЭТ, МРТ головного мозга; рентгенографии грудной клетки, КТ легких; тазовой ангиографии) определяются метастазы в малом тазу и отдаленных органах. При выявлении метастазов экстрагенитальной локализации возникает необходимость в консультации абдоминального хирурга, пульмонолога, нейрохирурга, уролога и т. д.
Лечение трофобластической болезни
Лечебная тактика при трофобластической болезни определяется ее формой и стадией. При пузырном заносе производится его вакуум-экстракция с контрольным кюретажем полости матки. Обязательно назначение контрацепции в течение года после удаления пузырного заноса. Химиотерапия при динамическом снижении ХГЧ не назначается. Во всех случаях трофобластической болезни со злокачественным течением показано проведение химиотерапии по одной из схем (метотрексат + дактиномицин; этопозид + цисплатин; дактиномицин + метотрексат + цисплатин + винкристин).
Хирургическая тактика обоснована при угрожающем кровотечении из первичной опухоли, перфорации стенки матки, резистентности к химиотерапии. У больных репродуктивного возраста возможно выполнение органосохраняющей гистеротомии с иссечением опухолевых тканей; у пациенток, не планирующих деторождение, целесообразно удаление матки методом надвлагалищной ампутации или радикальной гистерэктомии.
После курса терапии осуществляется мониторинг ХГЧ и характера менструального цикла, эхографический контроль, динамическая рентгенография легких, по показаниям – МРТ головного мозга в течение 2-3-х лет. Беременность женщинам, перенесшим трофобластическую болезнь, разрешается, не ранее, чем через 12-18 мес. после излечения.
Прогноз при трофобластической болезни
Правильность и своевременность лечения трофобластической болезни гарантирует в абсолютном большинстве случаев хороший прогноз. Химиотерапия позволяет вылечить 100% пациенток с неметастазирующим течением трофобластической болезни и около 70% с метастазирующими формами.
У молодых женщин обычно удается сохранить генеративную функцию. Дальнейшее наблюдение и обследование, ведение менограммы и контрацепция позволяют рассчитывать на успешное протекание последующей беременности. Рецидивы трофобластической болезни наблюдаются в 3-8% случаях.
Лечение метастатической гестационной трофобластической неоплазии высокого риска
Метастатическая гестационная трофобластическая неоплазия (ГТН) с одним или более факторов риска по клинической классификации или с суммарным прогностическим индексом по шкале FIGO > 7 баллов относится к заболеванию высокого риска. Таким больным часто показана ПХТ в сочетании с хирургическим лечением или облучением.
Следует подчеркнуть, что этим должны заниматься специалисты, имеющие опыт лечения этого относительно редкого заболевания, предпочтительно в специализированных центрах по лечению трофобластических опухолей. По данным этих клиник, выживаемость достигает 86 %. В отличие от неметастатической или метастатической ГТН низкого риска гистерэктомия, выполненная на первом этапе лечения, не улучшает исход при метастатических ГТН высокого риска.
Агрессивная полихимиотерапия (ПХТ) — важный компонент лечения таких больных. Многие годы в США стандартный режим лечения, вызывающий продолжительную ремиссию в 63—73 % случаев, включал три препарата: метотрексат, дактиномицин и хлорамбуцил или циклофосфамид (MAC).
Исследования в Southeastern Regional и Brewer Trophoblastic Disease Centers в начале 70-х годов прошлого века показали важность проведения ПХТ с самого начала лечения: при смене монохимиотерапии на ПХТ частота ремиссий составляла 14—39 %, а при первичном лечении пациенток с ГТН высокого риска по схеме MAC — 65—70 %. По некоторым данным, при очень высоком прогностическом индексе по шкале факторов риска ВОЗ выживаемость после проведения режима MAC низкая.
В конце 70-х годов XX в. Charing Cross group разработала сложный альтернирующий режим, включавший циклофосфамид, гидроксимочевину, дактиномицин, метотрексат/натрия фолинат, винкристин и доксорубицин (СНАМОСА). При использовании модификаций этого режима длительные ремиссии отмечены у 56—83 % больных ГТН высокого риска и складывалось впечатление о более низкой токсичности, чем при схеме MAC.
Однако сравнительное рандомизированное исследование MAC и СНАМОСА, выполненное GOG, показало сопоставимую частоту первичных ремиссий в 73 и 65 % случаев соответственно. Следует отметить, что после неудачи MAC следующая линия терапии оказалась эффективной у 5 из 6 пациенток, а при такой же ситуации с СНАМОСА — только у 1 из 7. Возможно, первоначальное воздействие малоэффективных дополнительных препаратов СНАМОСА снизило действенность следующей линии терапии в результате развития множественной лекарственной устойчивости или кумулятивной токсичности.
Кроме того, режим СНАМОСА обладал выраженной острой токсичностью, опасной для жизни: при IV степени ее частота составляла 45 %, тогда как при назначении MAC — только 9 %.

Это исследование дополнили Bowern соавт., включив в него 272 женщин с ГТН высокого риска. Полная ремиссия наступила в 213 (78 %) случаях; у 33 пациенток пришлось применить дополнительные методы лечения из-за неэффективности ЕМА/СО, при этом общая 5-летняя выживаемость составила 86,2 %. По данным другого небольшого ретроспективного исследования, частота полного ответа при первичном лечении ГТН высокого риска по схеме ЕМА/СО равнялась 65—94 %. Благодаря этим публикациям в настоящее время ЕМА/СО — наиболее широко используемый режим при первичном лечении ГТН высокого риска.
Большая часть литературы, посвященной другим режимам, представляет собой ретроспективный анализ результатов лечения относительно небольших групп пациенток с использованием несколько различных определений понятия «ГТН высокого риска». Независимо от выбранного режима активная повторяющаяся ПХТ — основа лечения заболевания высокого риска. Назрела необходимость проведения сравнительных рандомизированных исследований ЕМА/СО или новых комбинаций с MAC, но все осложняется относительной редкостью данной патологии.

a Иногда для лечения метастазов в головном мозге метотрексат назначают в виде 12-часовой в/в инфузии в дозе 500-1000 мг/м 2 с натрия фолинатом (антидот) в дозе до 15 мг каждые 6 ч в течение 48 ч или 30 мг каждые 12 ч в течение 48 ч.
b Некоторые исследователи применяют интратекальную инъекцию метотрексата в дозе 15 мг для профилактики или лечения метастазов в головном мозге.
Лечение метастазов в головном мозге дискутабельно; с целью ограничить острые геморрагические осложнения рекомендуют проводить комбинированную химиолучевую терапию. Показатель эффективности лечения при этом у первичных больных достигает 75 %. Однако такого же результата удалось добиться у пациенток, которые получали комбинированные режимы, состоявшие из системного введения высокихдоз метотрексата и его интратекальной инфузии, без облучения головного мозга. Наиболее эффективное лечение метастазов в печени и других органов с высоким риском поражения опухолью не установлен.
Даже при проведении интенсивной химиотерапии (XT) для стабилизации состояния больных из группы высокого риска, профилактики кровотечения из метастазов, устранения лекарственной резистентности или других осложнений может понадобиться дополнительное хирургическое вмешательство.
Лечение гестационной трофобластической неоплазии (ГТН) высокого риска после развития резистентности к химиотерапевтическим препаратам — исключительно трудная задача, которая в значительной степени зависит от предыдущей цитостатической терапии и кумулятивной токсичности. Если больные не получали XT с этопозидом, назначают схему ЕМА/СО; частота ремиссий при таком лечении составляет 71—82 %. Charing Cross group провела лечение 34 больных из группы высокого риска по схеме ЕМА/ЕР, которые раньше получали ЕМА/СО.

У пациенток с плато уровня ХГ во время проведения ЕМА/СО частота ремиссий составила 95 %, а при его повышении — 75 %. Эти режимы, применяемые в качестве терапии «спасения», вызывают более тяжелую миелосупрессию, чем при их использовании для первичного лечения.
В качестве терапии «спасения» для больных ГТН используют различные варианты комбинированных режимов, применяемых для лечения герминогенных опухолей яичка и яичников. По данным небольших исследований, частота ремиссий при назначении этопозида, платины (± блеомициy ± доксорубицин) и винбластина, блеомицина, цисплатина составляла 50—86 %, но отдаленная выживаемость была менее 50 %; использование этих комбинаций в качестве терапии «спасения» вызывает выраженную миелосупрессию. Согласно Sutton и соавт., XT с включением ифосфамида сопровождалась объективным ответом у 4 из 5 пациенток, но длительная ремиссия была отмечена только в 1 случае.
XT продолжают до нормализации уровня ХГ, а затем проводят еще три поддерживающих курса для элиминации всех клеток опухоли. Несмотря на использование чувствительных методов определения уровня ХГ и поддерживающую XT, примерно у 13 % больных ГТН высокого риска после достижения первоначальной ремиссии развиваются рецидивы.

Метастазы гестационной трофобластической неоплазии (ГТН) - обследование
В отличие от рака эндометрия гестационная трофобластическая неоплазия (ГТН) обычно метастазирует гематогенным путем. Инвазивный ПЗ и хориокарцинома обладают способностью к локальной инвазии миометрия, что открывает доступ к капиллярам и небольшим венам.
Распространение опухоли в субвагинальное венозное сплетение обусловливает метастазы во влагалище, а при поражении основной венозной системы матки формируются метастазы в параметрии и легких. Прямой выход клеток в систему кровообращения встречается редко, поэтому большая часть диссеминированных метастазов появляется только после развития метастазов в легких.
Возможна гематогенная диссеминация из легких через большой круг кровообращения. Чаще всего поражаются головной мозг, печень, ЖКТ и почки, но описаны метастазы в каждом органе. Лимфогенные метастазы при хориокарциноме и инвазивном ПЗ встречаются относительно редко. Необходимо помнить о преимущественно гематогенном метастазировании гестационной трофобластической неоплазии (ГТН), составляя план лучевых исследований.
Для пациенток с гестационной трофобластической неоплазией (ГТН) обследование перед началом лечения включает оценку клинических факторов риска, физикальное, лабораторные и лучевые исследования для определения локализации возможных метастазов и их количества.

Метастаз гестационной трофобластической неоплазии во влагалище в виде подслизистой кровоточащей опухоли, расположенной ниже уретры.
Влагалищные метастазы хорошо васкуляризованы, поэтому биопсия их опасна
Клинические факторы риска для оценки стадирования и лечения включают длительность заболевания (интервал времени с момента последней беременности), тип предшествующей беременности и предшествующее лечение. Особые клинические характеристики ТОПП, подтвержденной гистологическим исследованием, позволяют классифицировать ее отдельно от гестационной хориокарциномы или ГТН после эвакуации ПЗ.
Лабораторное исследование до начала химиотерапии (XT): основные гематологические и биохимические показатели, содержание ХГ. Важно подчеркнуть, что для стадирования принимают во внимание уровень ХГ, определенный непосредственно перед лечением злокачественной ГТН, а не во время эвакуации ПЗ.
Влагалищные метастазы гестационной трофобластической неоплазии (ГТН) чаще всего диагностируют при физикальном исследовании. Они поражают подслизистую основу передней стенки влагалища и выглядят как темные, часто синие, мягкие узлы. Возможно изъязвление или активное кровотечение. Из-за высокой васкуляри-зации этих поражений биопсия не показана. Если влагалище — единственное место локализации метастазов, то в большинстве случаев отмечают быструю реакцию на XT.
Для контроля активного кровотечения вначале лечения некоторым пациенткам может понадобиться тампонада влагалища или селективная эмболизация с применением методов интервенционной радиологии.
Рекомендуют следующие методы лучевой диагностики для стадирования гестационной трофобластической неоплазии (ГТН): рентгенографию или КТ грудной клетки, КГ или МРТ брюшной полости и таза, контрастная КТ или МРТ головного мозга. Для исключения маточной беременности перед началом XT проводят УЗИ органов таза. УЗИ и МРТ матки можно использовать для выявления маточных новообразований и участков инвазии гестационной трофобластической неоплазии (ГТН) в миометрий, но эти методы недостаточно чувствительны и специфичны и не заменяют мониторинга сывороточного ХГ как при диагностике ГТН, так и наблюдении за пациентками после лечения.
Примерно у 45 % больных к моменту установления диагноза ГТН имеются метастазы. В соответствии с распределением метастазов у пациенток, получавших первичное лечение по поводу злокачественных ГТН в Duke University Medical Center, очаги поражения чаще всего возникают в легких. Как правило, индикатором высокого риска метастазирования служат легочные метастазы, выявляемые при рентгенографии грудной клетки, или имеются другие симптомы метастатического поражения. Однако для установления диагноза неметастатической ГТН необходимо полное исследование на наличие метастазов, даже несмотря на отсутствие поражений на рентгенограмме грудной клетки.

Легочные метастазы гестационной трофобластической неоплазии встречаются в виде (а) солитарного узла или (б) диффузной инфильтрации
У 29—41 % пациенток, получавших лечение по поводу неметастатической гестационной трофобластической неоплазии (ГТН), были метастазы в легких, Fie определявшиеся при рентгенографии, fio выявленные при КТ. Клиническое значение скрытых метастазов в легких, если это единственное место внематочного распространения злокачественной ГТН, продолжает оставаться предметом дискуссий. Однако многие исследования у больных, получавших лечение по поводу метастазов высокого риска, включают лиц с первоначально нормальной рентгенограммой грудной клетки. Ошибка диагностики метастатической ГТН высокого риска на основании нормальной рентгенограммы грудной клетки и задержка в связи с этим активного лечения может иметь неблагоприятные последствия для больной.
Хирургические вмешательства могут быть включены в план лечения больных со злокачественной ГТН. Однако их редко применяют для постановки диагноза и определения стадии заболевания. Повторное выскабливание полости матки перед началом XT ГТН, возникшей после эвакуации ПЗ, — предмет активного обсуждения. По опыту University of Southern California, эта операция имела значение для лечения только 20 % женщин, а в 8 % случаев осложнилась перфорацией матки, потребовавшей выполнения гистерэктомии.
К другому мнению пришли Pezeshki и соавт., проанализировав результаты лечения 544 женщин, которым провели повторное выскабливание полости матки по поводу предполагаемой ГТН после эвакуации ПЗ, основываясь на показателях уровня ХГ. После повторной эвакуации содержимого полости матки у 368 (68 %) больных наступила спонтанная ремиссия. Из 251 пациентки с гистологическим диагнозом персистирующей, но неинвазивной ГТБ в 96 (38 %) случаях потребовалась XT, а среди 219 больных с отрицательным результатом гистологического исследования после повторного выскабливания слизистой оболочки матки — в 39 (18 %) случаях.
В США многие клиницисты лечат больных гестационной трофобластической неоплазией (ГТН) после эвакуации ПЗ без повторного выскабливания, поскольку оно может неблагоприятно повлиять на фертильность. Необходимость в других оперативных вмешательствах, таких как лапароскопия, торакотомия или краниотомия, при первичном установлении диагноза ГТН возникает редко.
Гестационная трофобластическая болезнь

Гестационная трофобластическая болезнь (ГТБ) — патология, которая включает в себя пузырный занос (полный и частичный), инвазивный пузырный занос, хориокарционому, трофобластическую опухоль плацентарного ложа и эпителиоидную трофобластическую опухоль. Данные заболевания встречаются не очень часто, однако представляют большую угрозу здоровью и жизни пациенток. В недалеком прошлом летальность от различных форм ГТБ могла достигать практически 100 % (например, в случаях с метастазировавшей хориокарциномой) [1]. И, не смотря на успехи, достигнутые в терапии данного заболевания, необходимо иметь настороженность в отношении ГТБ.
Частичный и полный пузырный занос
Предположительно, данная патология была описана еще в 400 году до н.э. Гиппократом. Но лишь в 1895 году пузырный занос связали с беременностью. Сейчас мы рассматриваем пузырный занос как аномалию беременности, при которой происходит пролиферация трофобласта (и цито-, и синцитиотрофобласта); ворсины хориона разрастаются в виде «пузырьков», и все это сочетается с отсутствием эмбриона/плода. Выделяют две формы пузырного заноса: полный и частичный [2].
Для полного пузырного заноса характерна невозможность определения эмбриона; наблюдается гиперплазия трофобласта с различным уровнем атипии, ворсины лишены сосудов. Формирование «пузырьков» носит генерализованный характер. Практически в 90 % случаев аномальная ткань имеет хромосомный набор 46ХХ, полученный путем дупликации ДНК гаплоидного сперматозоида. Генетический аппарат яйцеклетки дефектен либо неактивен либо вовсе отсутствует. Таким образом, весь генетический материал получен от отца (разумеется, кроме митохондриальной ДНК). В остальных случаях (≈ 10 %) клетки имеют набор 46XY или 46ХХ, который формируется путем слияния двух спермиев [1], [3].
Частичный пузырный занос — патология несколько иного рода. В этом случае возможно обнаружить некоторые ткани эмбриона; ворсины хориона отечны и варьируют по размеру и форме. Ворсины имеют фестончатую форму, из трофобласта образуются выступающие «включения», в ворсинах сохраняется кровоток. Одно из основных отличий частичного пузырного заноса от полного: гиперплазия и образование «пузырьков» носит фокальный характер, атипизм выражен крайне слабо. При этом хромосомный набор — триплоидный, зачастую 69XXY, который формируется путем слияния практически нормальной яйцеклетки и двух спермиев [1], [3].
Важно заметить: после полного пузырного заноса в 15-20 % случаев развивается трофобластическая неоплазия (инвазивный занос или хориокарцинома, см. ниже), тогда как при частичном заносе неоплазии развиваются менее, чем в 5 % случаев [1].
.

Рисунок 1. Полный пузырный занос
Клиническая картина при полном пузырном заносе носит неспецифический характер, симптомы у различных пациенток могут довольно сильно варьировать. Среди наиболее часто встречающихся проявлений следует выделить чрезмерное увеличение матки, анемию, токсемию, гипертиреоидизм и дыхательную недостаточность. Благодаря УЗИ и анализу на ХГЧ, диагностика полного пузырного заноса стала возможной уже в первом триместре, как правило, задолго до появления первых симптомов.
Клиника частичного пузырного заноса «мимикрирует» под картину неразвивающейся беременности. Может наблюдаться маточное кровотечение, при этом размеры матки находятся в пределах нормы [3].
Диагностика осуществляется в основном с помощью УЗИ и анализа на ХГЧ. При полном пузырном заносе хорошо заметна генерализованная гиперплазия, а повышение уровня ХГЧ помогает отличить пузырный занос от замершей беременности. В случае частичного пузырного заноса наиболее специфичными будут фокальные кистозные изменения в плаценте, а также увеличение гестационного мешка в полтора раза (это может свидетельствовать о триплоидии). Сочетание этих двух признаков дает достаточно высокую точность результата.
Уровень хорионического гонадотропина закономерно увеличивается при гиперплазии трофобласта. В случае полного пузырного заноса уровень ХГЧ может достигать 100 000 мЕД/мл и выше; при частичном такие цифры встречаются реже, однако увеличение, тем не менее, определяется также отчетливо [3].
Следует заметить, что окончательно диагностировать полный или частичный пузырный занос может только патологоанатом после гистологической верификации.
Лечение полного и частичного пузырного заносов заключается в удалении аномальной ткани из матки; наиболее оптимальным методом является вакуумная аспирация. Женщинам, которые более не планируют беременность, можно посоветовать гистерэктомию (особенно это оправданно в случае полного заноса) [3].
Однако пузырный занос сам по себе не представляет такой опасности, как возможные неопластические процессы, нередко развивающиеся впоследствии. Как мы помним, после полного пузырного заноса (а иногда и после частичного) могут развиваться хориокарцинома, инвазивный пузырный занос и другие патологические состояния, которые объединяют в группу гестационных трофобластических неоплазий (ГТН).
Для профилактики ГТН ранее даже рекомендовалась химиотерапия. Однако в сейчас такой подход считается неоправданным [4]. Доказательная база у профилактической противоопухолевой терапии достаточно низка, а гипотетическая польза в предотвращении ГТН так и остается лишь гипотетической, тогда как вред — вполне реальным. Потому пациентам с диагностированным пузырным заносом требуется систематическое наблюдение и постоянный мониторинг уровня ХГЧ (его резкое повышение, или «плато» (постоянно высокий уровень гормона) могут свидетельствовать о развитии осложнений в виде гестационных трофобластических неоплазий).
Следует заметить, что в дальнейшем беременность не противопоказана: женщина может зачать и выносить здорового ребенка. Однако нужно помнить, что риск повторного пузырного заноса увеличивается. Вероятность второго пузырного заноса составляет ≈ 1 %, третьего — ≈ 15–18 % [3].
Гестационная трофобластическая неоплазия
Гестационная трофобластическая неоплазия (ГТН) — термин, который объединяет четыре патологических состояния: инвазивный пузырный занос, хориокарциному, трофобластическую опухоль плацентарного ложа и эпителиоидную трофобластическую опухоль. ГТН — серьезное состояние, которое требует лечения химиотерапией. Но прежде, чем рассматривать неоплазии более предметно, следует заметить, что благодаря современным методам — мониторингу ХГЧ, систематическому наблюдению и химиотерапии — более 90 % случаев оканчиваются благоприятно [5].
Около 50 % ГТН — следствие полного или частичного пузырного заноса, 25 % из них развиваются после эктопической беременности и еще 25 % — вследствие преждевременных родов.
Клиническая картина разнится, наиболее общие симптомы — кровотечение, увеличение матки, текалютеиновые кисты. Но в половине случаев заболевание может не иметь каких-либо симптомов. Основной диагностический критерий ГТН — повышение уровня ХГЧ [6].
Международная федерация гинекологии и акушерства (FIGO) приводит следующую стадийность ГТН [7]:
1 стадия: заболевание развивается в пределах матки;
2 стадия: неоплазия распространилась за пределы матки, но ограничена другими генитальными структурами (влагалищем, широкой связкой);
3 стадия: ГТН метастазирует в легкие;
4 стадия: метастазирование в другие органы.
Лечение любой ГТН заключается в химиотерапии; зачастую достаточно какого-то одного препарата; на 4 стадии рекомендована комбинация терапевтических средств. Наиболее часто используются метотрексат и дактиномицин [6]. При толерантности к препаратам или рецидиве заболевания может быть рекомендован паклитаксел [8].
Также для ГТН с высоким риском метастазирования используется комбинация EMA/CO: этопозид, метотрексат, актиномицин-D (дактиномицин), циклофосфамид и винкристин [9].
Инвазивный пузырный занос
Инвазивным называется пузырный занос, который проникает в миометрий путем прямой «экспансии» в ткань или через вены. Примерно 10-17 % пузырных заносов будут инвазивными, и из них около 15 % — метастазируют (чаще всего в легкие или влагалище) [1].
.

Рисунок 2. Инвазивный пузырный занос
Инвазивный пузырный занос часто диагностируется клинически, так как инвазия в миометрий сопровождается кровотечением, болевым синдромом, а измерение уровня ХГЧ позволяет удостовериться в правильности диагноза. Поэтому терапию инвазивного заноса начинают даже без гистологической верификации [1].
Следует заметить, что данная патология может проявлять себя крайне необычно. Известны случаи внезапной смерти первородящей женщины [10], спонтанное почечное кровотечение [11], развитие инвазивного пузырного заноса с метастазами вследствие ятрогенной перфорации матки [12] и т.п.
Хориокарцинома
Примерно 2-3 % пузырных заносов трансформируются в хориокарциному — злокачественную опухоль, для которой характерна прямая инвазия в миометрий, аномальная гиперплазия и анаплазия трофобласта. Ворсины хориона отсутствуют, в ткани — обширные некрозы; нередки кровотечения [1].
.

Рисунок 3. Хориокарцинома
Хориокарцинома также имеет множество форм, и, пожалуй, заслуживает отдельного обсуждения. Следует только заметить, что метастазирует данная опухоль практически в любой орган и любую ткань [13].
Трофобластическая опухоль плацентарного ложа и эпителиоидная трофобластическая опухоль
Трофобластическая опухоль плацентарного ложа (ТОПЛ) — крайне редкое злокачественное заболевание. Оно возникает, когда в месте имплантации клетки трофобласта начинают делиться и проникать в миометрий между его мышечными волокнами [1].
.

Рисунок 4. Опухоль плацентарного ложа. Клетки опухоли проникают в ткань между мышечными волокнами миометрия [14].
Обычно подобная опухоль имеет форму полиповидного или узелкового плотного образования небольшого размера (≈ 5 см). Сама опухоль гомогенна, состоит из полигональных клеток с выраженным атипизмом; зачастую проникает глубоко в ткань [14], [15]. Как ни странно, ТОПЛ крайне хорошо реагирует на химиотерапию. В случае, если у пациентки нет метастазов — рекомендуется хирургическое лечение.
Эпителиоидная трофобластическая опухоль (ЭТ) — это еще более редкая форма ТОПЛ, которая несколько схожа с хориокарциномой. Представляет собой множество пролиферирующих одноядерных клеток трофобласта. В ряде случаев опухоль может частично заместить собой эпителий эндоцервикса.
Существенной разницы в лечении ТОПЛ и ЭТ нет, однако важно заметить, что эпителиоидная трофобластическая опухоль может возникнуть спустя годы после беременности [1], [16].
Читайте также:
- Коррекция алкалоза почками. Механизмы почечной коррекции алкалоза
- Гипердиагностика нейроциркуляторной дистонии. Дифференциация вегето-сосудистой дистонии с ИБС и гипертонической болезнью
- Мышцы промежности плода. Морфогенез мышц головы и шеи эмбриона
- Реваскуляризация в связи с острым коронарным синдромом
- Методика и этапы закрытия эзофагостомы
